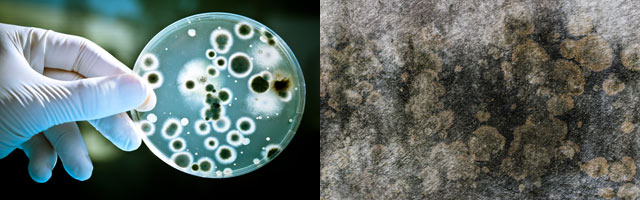

Добро пожаловать в BioHomEx — экспертов в области экологической безопасности вашего дома
Каждый день нас окружают миллионы микроорганизмов — бактерий, вирусов, грибков. Многие из них безвредны, но некоторые способны нанести серьёзный вред здоровью и разрушить комфортную среду в нашем жилье. Одним из наиболее опасных невидимых врагов является плесень — агрессивный микробиологический патоген, вызывающий аллергии, хронические заболевания и повреждения строительных конструкций.
BioHomEx — это команда профессионалов, специализирующихся на комплексной диагностике, выявлении причин появления плесени, лабораторных анализах и эффективных методах устранения грибковых поражений. Мы не просто устраняем последствия — мы ищем корень проблемы: нарушенный микроклимат, дефекты вентиляции, повышенную влажность или скрытые протечки.

Наша миссия — обеспечить здоровую и безопасную среду в каждом доме, офисе или общественном пространстве. Мы работаем на пересечении микробиологии, строительной экспертизы и экологии, чтобы защитить вас и ваших близких от скрытых угроз.
Вы получите:
![]() | ![]() | ![]() | ![]() | |
|---|---|---|---|---|
| Точную диагностику и профессиональные заключения; | Рекомендации по устранению и профилактике плесени; | Современные безопасные технологии обработки и защиты; | Сопровождение на каждом этапе — от обследования до восстановления микроклимата. |
❗ Помните: самостоятельное удаление плесени может быть опасным — споры легко распространяются и попадают в лёгкие. Не рискуйте здоровьем — доверьтесь специалистам.
Свяжитесь с нами прямо сейчас — специалисты BioHomEx помогут вам разобраться в ситуации и предложат лучшее решение.
Ваш дом — ваша крепость. Сделаем её действительно безопасной.



